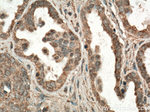
FIS1 Antibody in Immunohistochemistry (Paraffin) (IHC (P))

Search
Proteintech
FIS1 Monoclonal Antibody (2F10E1)
{{$productOrderCtrl.translations['antibody.pdp.commerceCard.promotion.promotions']}}
{{$productOrderCtrl.translations['antibody.pdp.commerceCard.promotion.viewpromo']}}
{{$productOrderCtrl.translations['antibody.pdp.commerceCard.promotion.promocode']}}: {{promo.promoCode}} {{promo.promoTitle}} {{promo.promoDescription}}. {{$productOrderCtrl.translations['antibody.pdp.commerceCard.promotion.learnmore']}}
产品信息
66635-1-IG
种属反应
宿主/亚型
分类
类型
克隆号
抗原
偶联物
形式
浓度
规格
纯化类型
保存液
内含物
保存条件
运输条件
产品详细信息
Immunogen sequence: MEAVLNELV SVEDLLKFEK KFQSEKAAGS VSKSTQFEYA WCLVRSKYND DIRKGIVLLE ELLPKGSKEE QRDYVFYLAV GNYRLKEYEK ALKYVRGLLQ TEPQNNQAKE LERLIDKAMK KDGLVGMAIV GGMALGVAGL AGLIGLAVSK SKS (1-152 aa encoded by BC009428)
靶标信息
Fis1, a 17KDa integral membrane protein, is a novel member of mitochondrial fission machinery. It consists of a central leucine-zipper domain, a coiled-coil region, a tetratricopeptide repeat domain and a C-terminal transmembrane domain. It is a human orthologue of Fis1p (S.cerevisiae) and is localized in the outer mitochondrial membrane. Fis1 acts as a pro-apoptotic factor and plays a vital role in the regulation of mitochondrial fission. It interacts with DLP1 and Mdv1p and facilitates Dnm1p recruitment to the functional fission complex, thereby inducing apoptosis. Role of Fis1 has also been implicated in growth and division of peroxisomes. Loss of Fis1 inhibits apoptosis and results in elongation of mammalian mitochondria.
仅用于科研。不用于诊断过程。未经明确授权不得转售。
生物信息学
蛋白别名: FIS1 homolog; fission 1 (mitochondrial outer membrane) homolog; H_NH0132A01.6; hFis1; Mitochondrial fission 1 protein; mitochondrial fission molecule; tetratricopeptide repeat domain 11; Tetratricopeptide repeat protein 11; TPR repeat protein 11
基因别名: CGI-135; FIS1; TTC11
UniProt ID: (Human) Q9Y3D6
Entrez Gene ID: (Human) 51024